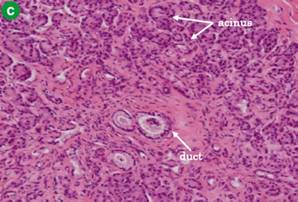

CASE REPORT
JOP. J Pancreas (Online) 2012 Mar 10; 13(2):235-238.
Elevation of Pancreatic Enzymes in Gallbladder Bile Associated with Heterotopic Pancreas. A Case Report and Review of the Literature
Asahi Sato, Masaji Hashimoto, Kazunari Sasaki, Masamichi Matsuda, Goro Watanabe
Department of Digestive Surgery, Toranomon Hospital. Tokyo, Japan
ABSTRACT
Context This is the first report associating heterotopic pancreas in the gallbladder and elevated pancreatic enzymes in bile. Case report A 60-year-old woman underwent abdominal ultrasonography at a medical check-up, revealing a nodular protrusion at the neck of the gallbladder. It seemed likely to be a lymph node, but we could not exclude the possibility of gallbladder cancer. In order to make a correct diagnosis, laparoscopic cholecystectomy was successfully performed. Pathological examination revealed heterotopic pancreatic tissue in the gallbladder wall. In addition, we detected elevated levels of amylase and lipase in gallbladder bile. Conclusions Preoperative diagnosis of heterotopic pancreas in the gallbladder is difficult. However, an increase of pancreatic enzymes in gallbladder bile may potentially play an important role in the occurrence of acalculous cholecystitis and biliary cancer. We need more accumulation of cases to know the true significance of this anomaly.
INTRODUCTION
Heterotopic pancreas is defined as tissue that is histologically similar to normal pancreas but appearing at an extra-pancreatic site and showing no anatomical or vascular connection with the original pancreas. Common sites of involvement include the upper gastrointestinal tract, such as the stomach, duodenum, proximal jejunum, and Meckel’s diverticulum [1]. The clinical significance of heterotopic pancreas of the gallbladder, a relatively rare abnormality, is unclear. This report describes the findings regarding an asymptomatic patient presenting with heterotopic pancreas in the neck of the gallbladder. We demonstrated elevated levels of amylase and lipase in gallbladder bile of a patient with heterotopic pancreas for the first time in the world. This case suggests the existence of a potential relationship between heterotopic pancreas and biliary tract disease. It might be possible that we predict the future risk of biliary tract disease of such patients by measuring pancreatic enzymes in bile. However, we need more accumulation of cases to prove the true significance of the pathological condition.
CASE REPORT
A 60-year-old woman presenting with no symptoms and no history of biliary colic underwent routine abdominal ultrasonography (US) as part of a medical check-up. The US results revealed a nodular protrusion sized 15 mm at the neck of the gallbladder (Figure 1). Despite this abnormality, the patient’s abdomen was unremarkable on physical examination. Neither the results of routine blood tests, which revealed serum carcinoembryonic antigen concentration (CEA) and CA 19-9 levels within normal ranges, nor magnetic resonance cholangiopancreatography (Figure 2), which detected no pancreaticobiliary maljunction, indicated any other abnormality. Although the nodular protrusion seemed likely to be a lymph node, gallbladder cancer could not be ruled out because it was a wide-based protrusion. To determine whether the protrusion was cancerous, laparoscopic cholecystectomy was performed using the standard 4-port technique for diagnosis and treatment. The intraoperative findings indicated that the protrusion was likely not cancerous. The postoperative course was uneventful and the patient discharged on the fourth postoperative day without any complications.

|
Figure 1. Abdominal ultrasound showing thickened lesion on neck of gallbladder (arrow). |

|
Figure 2. Magnetic resonance cholangiopancreatography revealing absence of pancreaticobiliary maljunction. |
Macroscopically, diffuse thickening of the gallbladder wall and nodular thickening (7 mm in diameter) was observed near the cystic duct (Figure 3a). Histopathological examination revealed pancreatic acini and ducts without islets of Langerhans inside the nodular lesion and diffuse hyperplastic cholecystopathy (Figure 3bc). Based on these findings, the case was histologically diagnosed as adenomyomatosis and heterotopic pancreas in the gallbladder wall. We routinely measured the constituent of the bile in the resected gallbladder. We detected elevated amylase and lipase levels of 6,372 IU/L and 9,144 IU/L, respectively, compared to median levels of 24 IU/L and 246 IU/L, respectively, at the presenting in our hospital. For reference, the mean levels of amylase and lipase in bile in patients with pancreaticobiliary maljunction are 127,901 IU/L and 222,692 IU/L, respectively, in our hospital.

|
Figure 3. Image of protruding lesion near the cystic duct (a. arrow). The microscopy reveals pancreatic acinar and duct content in the layer of subserosa (b. H&E, x100; c. H&E, x400). |
DISCUSSION
Heterotopic pancreas is a congenital anomaly characterized by growth of aberrant tissue mimicking normal pancreas without ductal or vascular continuity to the original gland. Heterotopic pancreas has traditionally been presumed to result from an error during embryological development, and is often only detected incidentally on laparotomy or autopsy. A recent theory contends that abnormalities in the Notch signaling system, specifically abnormalities in hairy and enhancer of split-1 (Hes-1), a main effector of Notch signaling required for lesion-appropriate pancreatic differentiation in the developing foregut endoderm [2], lead to development of heterotopic pancreatic tissue. The incidence of heterotopic pancreas has been reported to range from 0.55% to 13.7% at autopsy [2], but the true incidence is not known because most patients are asymptomatic. Common sites of involvement include the upper gastrointestinal tract, such as the stomach, duodenum, and proximal jejunum. Although heterotopic pancreas in the gallbladder is uncommon, pancreatic heterotopias causing acute and chronic cholecystopathy, gallbladder neck obstruction, and gallbladder perforation have been reported [3, 4, 5].
We reviewed 18 available cases of heterotopic pancreas of the gallbladder reported in the English literature (Table 1) [1, 3, 4, 5, 6, 7, 8, 9, 10, 11, 12, 13, 14, 15, 16]. Preoperative diagnoses could only be made for 13 cases, with 10 diagnosed as gallstones, two as polyps, and one as cancer, with the diagnoses of the remaining 5 being unclear. Symptoms associated with cholecystitis were observed for 7 cases, but no gallstones were detected for these cases. The diameter of the heterotopic pancreas lesion of the 18 cases ranged from 4 to 20 mm (mean: 11 mm). In 15 cases, full components of pancreas, such as acini, ducts, and islets of Langerhans, were detected by histological examination of the resected specimen. None of the reports measured the concentration of pancreatic enzymes in the gallbladder bile.
|
Table 1. Reported cases of heterotopic pancreas in the gallbladder. |
|||||||||
|
Case |
Author |
Age |
Sex |
Preoperative diagnosis |
Location in gallbladder |
Diameter |
Von Heinrich’s classification [17] |
Symptomatic |
Gallbladder stone |
|
#1 |
Beltran et al. [1] |
8 |
Male |
GBS |
Body |
4 mm |
I |
+ |
+ |
|
#2 |
Beltran et al. [1] |
22 |
Female |
GBS |
Neck |
5 mm |
I |
+ |
+ |
|
#3 |
Shiwani et al. [3] |
20 |
Female |
GBS |
Unknown |
Unknown |
I |
+ |
+ |
|
#4 |
Ben-Brauch et al. [4] |
45 |
Male |
GBS |
Neck |
10 mm |
I |
+ |
+ |
|
#5 |
Mrak et al. [5] |
75 |
Female |
GBS |
Neck |
5 mm |
I |
+ |
+ |
|
#6 |
Weppner et al. [6] |
26 |
Female |
GBS |
Neck |
10 mm |
I |
+ |
- |
|
#7 |
Elpek et al. [7] |
40 |
Male |
Unknown |
Neck |
9 mm |
I |
+ |
- |
|
#8 |
Meshikhes et al. [8] |
23 |
Female |
GBS |
Fundus |
10 mm |
I |
+ |
+ |
|
#9 |
Mboti et al. [9] |
23 |
Female |
GBS |
Unknown |
Unknown |
I |
+ |
- |
|
#10 |
Bhana et al. [10] |
47 |
Female |
Unknown |
Neck |
20 mm |
I |
+ |
- |
|
#11 |
Murakami et al. [11] |
49 |
Female |
Polyp |
Unknown |
5 mm |
II |
- |
- |
|
#12 |
Kondi-Paphiti et al. [12] |
58 |
Female |
Polyp |
Unknown |
20 mm |
I |
+ |
- |
|
#13 |
Kondi-Paphiti et al.[12] |
48 |
Female |
GBS |
Unknown |
15 mm |
I |
+ |
+ |
|
#14 |
Kondi-Paphiti et al. [12] |
53 |
Female |
Cancer |
Unknown |
20 mm |
I |
+ |
+ |
|
#15 |
Inceoglu et al. [13] |
55 |
Female |
GBS |
Neck |
13 mm |
II |
+ |
+ |
|
#17 |
Qizilbash [14] |
54 |
Male |
Unknown |
Unknown |
5 mm |
I |
+ |
- |
|
#18 |
Elfving [15] |
59 |
Female |
Unknown |
Unknown |
Unknown |
I |
+ |
+ |
|
#19 |
Vidgoff et al. [16] |
52 |
Male |
Unknown |
Unknown |
10 mm |
I |
+ |
- |
|
I: acinus, ducts and the islet of Langerhans; II: acinus and ducts; III: acinus only (Von Heinrich’s classification is defined by components of the heterotopic pancreatic tissue [17]). GBS: gallbladder stone |
|||||||||
The elevated levels of gallbladder bile amylase and lipase concentration observed in this study indicate that heterotopic pancreas tissue plays a role in exocrine functioning. As such, it is possible that the exocrine activity of heterotopic pancreas could cause pain and lead to the onset of acalculous cholecystitis. Furthermore, as does the pathophysiology resulting from pancreaticobiliary maljunction, elevation of pancreatic enzymes could eventually damage the biliary tract and gallbladder mucosa, leading to the development of gallbladder cancer. We consider that moderate elevation of pancreatic enzymes in gallbladder bile may be the feature in patients with heterotopic pancreas locating at gallbladder, as compared with the value of patients with pancreaticobiliary maljunction.
Generally, preoperative diagnosis of heterotopic pancreas in the gallbladder is difficult because of its rarity, leading this diagnosis to be unlikely to be considered in differential diagnosis. It is distant to make correct diagnosis for heterotopic pancreas preoperatively at present. However, we considered that measuring pancreatic enzymes in bile of the resected gallbladder might be useful for prediction of future risk of biliary cancer.
In conclusion, observation of an association between heterotopic pancreas in the gallbladder and elevated levels of pancreatic enzymes in bile (reported for the first time in this study) suggests the existence of a relationship between heterotopic pancreas and biliary disorders. Further research and examination of similar cases is required for confirmation of this relationship and further assessment of the clinical significance of heterotopic pancreas.
Received September 28th, 2011 - Accepted January 23rd, 2012
Key words Acalculous Cholecystitis; Biliary Tract Neoplasms; Cholecystectomy, Laparoscopic
Conflicts of interest The authors have no potential conflicts of interest
Correspondence
Asahi Sato
Department of Digestive Surgery
Toranomon Hospital
2-2-2 Toranomon, Minato-ku
Tokyo 105-8470
Japan
Phone: +81-3.3588.1111
Fax:
+81-3.3582.7068
E-mail: asahi.sato39@gmail.com
References
1. Beltran MA, Barria C. Heterotopic pancreas in the gallbladder: the importance of an uncommon condition. Pancreas. 2007;34:488-491 (More details: [1]).
2. Artavanis-Tsakonas S, Rand MD, Lake RJ. Notch signaling: cell fate control and signal integration in development. Science. 1999;284:770-776 (More details: [2]).
3. Shiwani MH, Gosling J. Heterotopic pancreas of the gallbladder associated with chronic cholecystitis. JOP. 2008;9:30-32 (More details: [3]).
4. Ben-Baruch D, Sandbank Y, Wolloch Y. Heterotopic pancreatic tissue in the gallbladder. Acta Chir Scand. 1986;152:557-558 (More details: [4]).
5. Mrak K, Eberl T, Tschmelitsch J, Langner C. Heterotopic pancreatic tissue in the cystic duct: Complicating factor or coexisting pathology. South Med J. 2010;103:471-473 (More details: [5]).
6. Weppner JL, Wilson MR, Ricca R, Lucha PA Jr. Heterotopic pancreatic tissue obstructing the gallbladder neck: a case report. JOP. 2009;10:532-534 (More details: [6]).
7. Elpek GO, Bozova S, Kupesiz GY, Ogus M. An unusual cause of cholecystitis: heterotopic pancreatic tissue in the gallbladder. World J Gastroenterol. 2007;13:313-315 (More details: [7]).
8. Meshikhes AW, Al-Jaroof AH, Atassi R. Heterotopic pancreas in the gallbladder. Saudi Med J. 2003;24:907-908 (More details: [8]).
9. Mboti F, Maassarani F, De Keuleuneer R. Cholecystitis associated with heterotopic pancreas. Acta Chir Belg. 2003;103:110-112 (More details: [9]).
10. Bhana BD, Chetty R. Heterotopic pancreas-an unusual cause of cholecystitis. South Afr J Surg. 1999;37:105-107 (More details: [10]).
11. Murakami M, Tsutsumi Y. Aberrant pancreatic tissue accompanied by heterotopic gastric mucosa in the gallbladder. Path Int. 1999;49:580-582 (More details: [11]).
12. Kondi-Paphiti A, Antoniou AG, Kotsis T, Polimeneas G. Aberrant pancreas in the gallbladder wall. Eur Radiol. 1997;7:1064-1066 (More details: [12]).
13. Inceoglu R, Dosluoglu HH, Kullu S, Ahiskali R, Doslu FA. An unusual cause of hydropic gallbladder and biliary colic-heterotopic pancreatic tissue in the cystic duct: Report of a case and review of the literature. Surg Today. 1993;23:532-534 (More details: [13]).
14. Qizilbash AH. Acute pancreatitis occurring in heterotopic pancreatic tissue in the gallbladder. Can J Surg. 1976;19:413-414 (More details: [14]).
15. Elfving G. Heterotopic pancreatic tissue in the gallbladder wall: report of a case. Acta Chir Scand. 1959;118:32-36 (More details: [15]).
16. Vidgoff IJ, Lewis A. Acute hemorrhage from aberrant pancreatic tissue in the gallbladder. Califo Med. 1961;94:317-319 (More details: [16]).
17. Von Heinrich H. A contribution to the histology of the so-called accessory pancreas. Virchows Arch A Pathol Anat Histopatol. 1909;198:392-401. (More details: [17]).